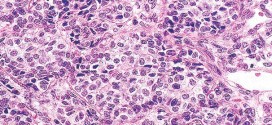
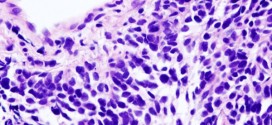
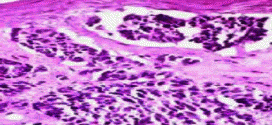

El carcinoma invasor de cuello uterino. Durante los primeros años de vida de una persona, las células normales se dividen más rápidamente para permitir el crecimiento. El cuerpo está compuesto por billones de células vivas. Las células normales del cuerpo crecen, se dividen formando nuevas células y mueren de manera ordenada. Una vez que se llega a la edad adulta, …
Leer MásEnfermedades
CARCINOMA INVASOR DE LA MATRIZ
El carcinoma invasor de la matriz. Los virus del papiloma humano (VPH) de los tipos 16 y 18 son los principales tipos que se asocian al cáncer ginecológico y genital. A saber, sin olvidar a los demás. Tumor maligno casi siempre y especialmente el formado por células epiteliales. Durante los primeros años de vida de una persona, las células normales …
Leer MásCARCINOMA INVASOR DE OVARIO
El carcinoma invasor de ovario. Los virus del papiloma humano (VPH) de los tipos 16 y 18 son los principales tipos que se asocian al cáncer ginecológico y genital. A saber, sin olvidar los demas. Tumor maligno casi siempre y especialmente el formado por células epiteliales. La incidencia anual del cáncer de ovario en países desarrollados se estima en 17-19 casos por …
Leer MásCARCINOMA INVASOR GINECOLÓGICO
El carcinoma invasor ginecológico. Por orden de frecuencia, los cánceres genitales son los siguientes: mama, endometrio, cérvix, ovario, vulva y vagina. Cada uno tiene sus peculiaridades epidemiológicas y diagnósticas. Todos los factores que exponemos a continuación deben tenerse en cuenta pero por supuesto no son determinantes. Como en todos los cánceres en general existen factores genéticos hereditarios que se manifiestan …
Leer MásCARCINOMA INVASOR DE CERVIX
El carcinoma invasor de cérvix. El cérvix, o cuello uterino, es parte del sistema reproductor de la mujer. Está ubicado en la pelvis. El cérvix es la parte inferior, estrecha, del útero (matriz). El cérvix es un canal: El cérvix conecta el útero con la vagina. Durante el período menstrual, la sangre corre desde el útero por el cérvix hacia la vagina. La vagina conduce al exterior …
Leer MásCARCINOMA INVASIVO DE MAMA
El carcinoma de mama. Durante los primeros años de vida de una persona, las células normales se dividen más rápidamente para permitir el crecimiento. El cuerpo está compuesto por billones de células vivas. Las células normales del cuerpo crecen, se dividen formando nuevas células y mueren de manera ordenada. Una vez que se llega a la edad adulta, la mayoría …
Leer MásCARCINOMA INFLAMATORIO DE MAMA
El carcinoma inflamatorio de mama. Durante los primeros años de vida de una persona, las células normales se dividen más rápidamente para permitir el crecimiento. El cuerpo está compuesto por billones de células vivas. Las células normales del cuerpo crecen, se dividen formando nuevas células y mueren de manera ordenada. Una vez que se llega a la edad adulta, la …
Leer MásCARCINOMA EPITELIAL DE OVARIO
El carcinoma epitelial de ovario. Durante los primeros años de vida de una persona, las células normales se dividen más rápidamente para permitir el crecimiento. El cuerpo está compuesto por billones de células vivas. Las células normales del cuerpo crecen, se dividen formando nuevas células y mueren de manera ordenada. Una vez que se llega a la edad adulta, la …
Leer MásCARCINOMA ADENOIDE QUÍSTICO DE GLÁNDULA SUBLINGUAL
El carcinoma adenoide quístico de glándula sublingual. Durante los primeros años de vida de una persona, las células normales se dividen más rápidamente para permitir el crecimiento. El cuerpo está compuesto por billones de células vivas. Las células normales del cuerpo crecen, se dividen formando nuevas células y mueren de manera ordenada. Una vez que se llega a la edad …
Leer MásCARCINOMA ADENOIDE QUÍSTICO DE LAS GLÁNDULAS SALIVARES
El carcinoma adenoide quístico de las glándulas salivares. Durante los primeros años de vida de una persona, las células normales se dividen más rápidamente para permitir el crecimiento. El cuerpo está compuesto por billones de células vivas. Las células normales del cuerpo crecen, se dividen formando nuevas células y mueren de manera ordenada. Una vez que se llega a la …
Leer MásCARCINOMA ADENOIDE QUÍSTICO SUBMAXILAR
El carcinoma adenoide quístico submaxilar. La glándula submaxilar o submandibular se sitúa en la celda submaxilar, en la parte alta y central del cuello, bajo la rama horizontal de la mandíbula. Es una glándula lobulada, de consistencia firme, de color rosado. En el área de la glándula submaxilar existen numerosos grupos ganglionares, los que se dividen en pre y retro …
Leer MásCARCINOMA ADENOIDE QUÍSTICO DE LA TRÁQUEA
El carcinoma adenoide quístico de la tráquea. Un tumor de la tráquea es un crecimiento anormal que se forma en su tráquea. La tráquea transporta el aire que respira por los pulmones. Que comienza justo por debajo del nivel de la laringe (caja de voz) y termina en el pecho, donde las vías respiratorias se dividen en las dos ramas …
Leer MásCARCINOMA EPIDERMOIDE DEL SENO MAXILAR
El carcinoma epidermoide del seno maxilar. Durante los primeros años de vida de una persona, las células normales se dividen más rápidamente para permitir el crecimiento. El cuerpo está compuesto por billones de células vivas. Las células normales del cuerpo crecen, se dividen formando nuevas células y mueren de manera ordenada. Una vez que se llega a la edad adulta, …
Leer MásCARCINOMA EPIDERMOIDE DE FOSA NASAL
El carcinoma epidermoide de fosa nasal. Durante los primeros años de vida de una persona, las células normales se dividen más rápidamente para permitir el crecimiento. El cuerpo está compuesto por billones de células vivas. Las células normales del cuerpo crecen, se dividen formando nuevas células y mueren de manera ordenada. Una vez que se llega a la edad adulta, …
Leer MásCARCINOMA EPIDERMOIDE DE BORDE LATERAL DE LENGUA MÓVIL
El carcinoma epidermoide de borde lateral de lengua móvil. Durante los primeros años de vida de una persona, las células normales se dividen más rápidamente para permitir el crecimiento. El cuerpo está compuesto por billones de células vivas. Las células normales del cuerpo crecen, se dividen formando nuevas células y mueren de manera ordenada. Una vez que se llega a …
Leer MásCARCINOMA EPIDERMOIDE DE LA CAVIDAD BUCOFARINGEA
El carcinoma epidermoide de la cavidad bucofaríngea. Durante los primeros años de vida de una persona, las células normales se dividen más rápidamente para permitir el crecimiento. El cuerpo está compuesto por billones de células vivas. Las células normales del cuerpo crecen, se dividen formando nuevas células y mueren de manera ordenada. Una vez que se llega a la edad …
Leer MásCARCINOMA EPIDERMOIDE DE HIPOFARINGE
El carcinoma epidermoide de hipofaringe. La hipofaringe se extiende desde el plano del hueso hioides por encima del plano del borde inferior del cartílago cricoideo más abajo. La hipofaringe se compone de las siguientes tres partes que no incluye la laringe: El seno piriforme. El área poscricoidea. La pared faríngea posterior. El drenaje linfático de la faringe desemboca en los …
Leer MásCARCINOMA EPIDERMOIDE DE OÍDO MEDIO
El carcinoma epidermoide de oído medio. Los carcinomas epidermoide de oído medio son raros 1-2/1000000/año. CAE/oído medio: 10/1. Tipo histológico más frecuente Ca epidermoide (70%), seguido del Ca basocelular. Durante los primeros años de vida de una persona, las células normales se dividen más rápidamente para permitir el crecimiento. El cuerpo está compuesto por billones de células vivas. Las células …
Leer MásCARCINOMA EPIDERMOIDE DE ESÓFAGO
El carcinoma epidermoide de esófago. El esófago es el tubo hueco, muscular que transporta los alimentos y los líquidos desde la garganta al estómago. La pared del esófago comprende varias capas de tejido, incluyendo la membrana mucosa, músculo y tejido conjuntivo. Durante los primeros años de vida de una persona, las células normales se dividen más rápidamente para permitir el crecimiento. El cuerpo está compuesto por billones …
Leer MásCARCINOMA EPIDERMOIDE DE CERVIX
El carcinoma epidermoide de cérvix. El cérvix es el cuello del útero que se abre a la vagina. El carcinoma epidermoide de cérvix (cuello uterino (CECU) es la segunda neoplasia más frecuente en la mujer, después del cáncer de mama. Durante los primeros años de vida de una persona, las células normales se dividen más rápidamente para permitir el crecimiento. …
Leer Más Binipatia e higienismo Medicina natural alternativa, plantas medicinales y remedios caseros naturales
Binipatia e higienismo Medicina natural alternativa, plantas medicinales y remedios caseros naturales